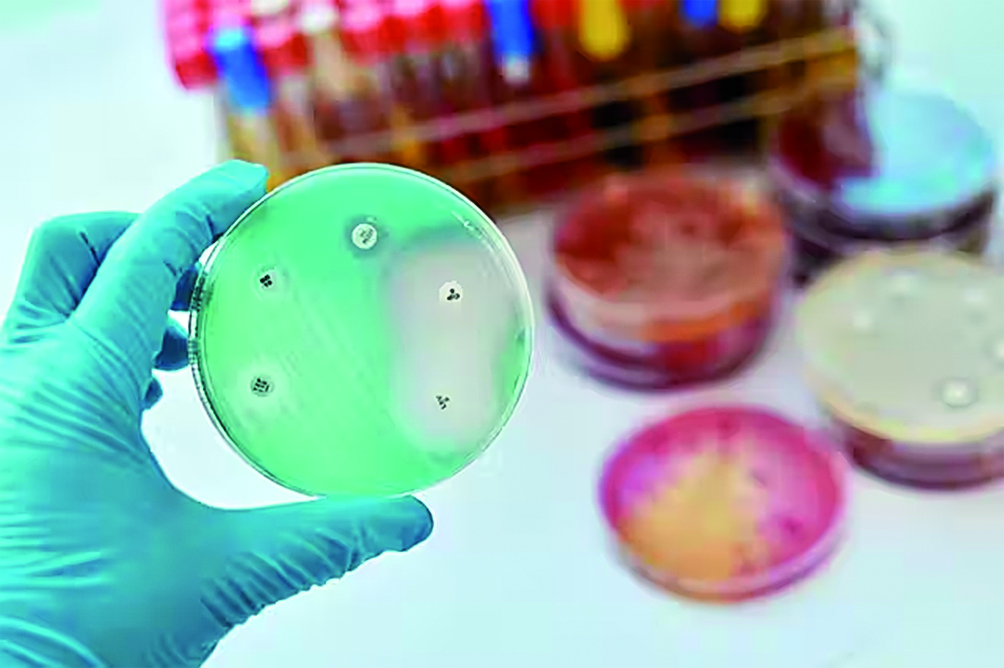

La Cámara de Diputados aprobó y envió al Senado el proyecto de ley sobre prevención y control de la resistencia a los antimicrobianos, cuyos objetivos son el cuidado de la salud.
La iniciativa, impulsada por la presidenta de la comisión de Acción Social y Salud Pública, Mónica Fein (Socialista), y el legislador del Frente de Todos Daniel Gollán, sumó 199 votos a favor y uno en contra.
El proyecto regula la venta de los antibióticos al establecer que "todas las especialidades medicinales cuyo ingrediente farmacéutico activo (IFA) tenga actividad antimicrobiana sistémica debe ser la de "venta bajo receta archivada"".
Además prohíbe "toda forma de anuncio al público de todas las especialidades medicinales cuyo ingrediente farmacéutico activo (IFA) tenga actividad antimicrobiana sistémica". El proyecto crea el Plan Nacional de Acción para la Prevención y Control de la Resistencia a los Antimicrobianos y las Infecciones Asociadas al Cuidado de la Salud.
Una de sus metas es "promover el uso apropiado de los antimicrobianos para minimizar su utilización innecesaria sin comprometer la salud humana y animal, promover las medidas necesarias para la regulación y fiscalización de antimicrobianos y concientizar, informar y educar sobre la resistencia a los antimicrobianos". Durante el breve debate del proyecto, Gollán señaló que "se produce una pérdida cada vez más acelerada de los efectos de los antimicrobianos; entre otras cosas por problemas de prescripción".
"Se prescriben a veces antibióticos que no hacen falta, o hay farmacias que dan medicamentos sin recetas, e incluso hay mucha automedicación", advirtió el exministro de Salud nacional y bonaerense. En ese sentido, advirtió que "estamos ante una situación grave; porque se banaliza la utilización de medicamentos".
Por último, ejemplificó con datos: "Hay una intencionalidad comercial, porque existen tratamientos de 3 pastillas por 7 días (total 21) y los blíster son de 8 o de 16 pastillas; y las que sobran por ahí las termina tomando tiempo después un familiar que tiene los mismos síntomas".
"Superbacterias", microbios resistentes a antibióticos convencionales
La prescripción no controlada de antimicrobianos y la propia adaptación de las bacterias a los antibióticos ha provocado la aparición, sobre todo en hospitales y clínicas, de cepas bacteriales resistentes a tratamientos antibióticos. Son las famosas y temidas "enfermedades intrahospitalarias", cuyos agentes patógenos, derivados de generaciones precedentes que desarrollaron resistencia (ya sea en su citoplasma o en su membrana celular) por selección natural o mutación genética, son muy difíciles de tratar, y necesitan antibióticos cada vez más potentes.
El riesgo de que tales enfermedades propias de los nosocomios escapen hacia el resto de la sociedad, o que cualquier otra cepa endémica desarrolle una resistencia extra a los medicamentos actuales no es lejano. Desde hace décadas que la OMS viene advirtiendo tanto sobre la venta o prescripción indiscriminada y a veces innecesaria de antibióticos como de la automedicación o la interrupción de los tratamientos. Esto último puede provocar que ciertas bacterias resistentes de la colonia sobrevivan, multiplicándose y empeorando el cuadro del paciente. Existe también la creencia popular de que ante cualquier enfermedad los antibióticos son la respuesta, cuando se sabe que las patologías virales son inmunes a este remedio dada su naturaleza no bacteriana.
Por agencia Télam
